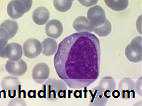

Lab. 4 Nucleus
Neutroplil
Multilobed nucleus((irregular shape
Monocyte
nucleus(Kidney shape)
(Cuboidal cells)
(nucleus(Spherical shape
Lymphocyte
One centric nucleus
One nucleus (oval in shape)
CentericPseudo stratified epithelial tissue
((Different location
Skeletal muscle cells
nucleus(oval in shape )(multinucliated cells)
Osteoclast cells
Multinucleated cells
Adipose cells
Nucleus(oval in shape)Eccentric nucleus